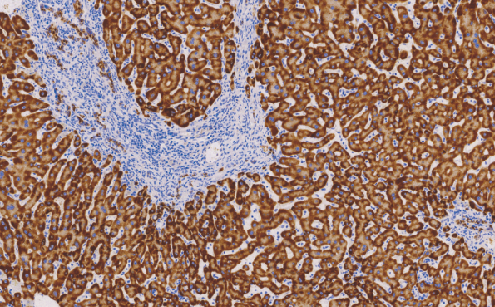
鼠抗人H*BsAg单克隆抗体  TDCHM-0121

万千商家帮你免费找货
0 人在求购买到急需产品
- 详细信息
- 文献和实验
- 技术资料
- 形态:
Liquit
- 保存条件:
-20℃
- 克隆性:
单克隆
- 适应物种:
Human,(predicted:Mouse,Rat,)
- 保质期:
1年
- 抗原来源:
peptiede
- 目录编号:
TDCHM-0121
- 级别:
科研级
- 库存:
88
- 供应商:
武汉天德
- 宿主:
鼠
- 浓度:
1mg/ml
- 抗体英文名:
H*BsAg
- 抗体名:
HBsAg
- 规格:
1ml工作液
H*BsAg鼠抗人H*BsAg单克隆抗体
H*BsAg是乙型肝炎病毒的表面抗原。主要用于肝炎的诊断,尤其在肝穿刺活检的乙型肝炎病毒的检测。可用于肝硬化、肝细胞肝癌的病因研究。此抗体还有助于对肝炎相关性肾炎的诊断及鉴别诊断
- 货号:TDCHM-0121
- 克隆号:A10F1
- 阳性部位:胞质
- 适用组织:石蜡切片 /冰冻切片
- 预处理:热修复
风险提示:丁香通仅作为第三方平台,为商家信息发布提供平台空间。用户咨询产品时请注意保护个人信息及财产安全,合理判断,谨慎选购商品,商家和用户对交易行为负责。对于医疗器械类产品,请先查证核实企业经营资质和医疗器械产品注册证情况。
文献和实验该产品被引用文献
抗体使用小技巧_技术资料_丁香通 (biomart.cn)
技术资料暂无技术资料 索取技术资料
文献支持
鼠抗人H*BsAg单克隆抗体 TDCHM-0121
询价









